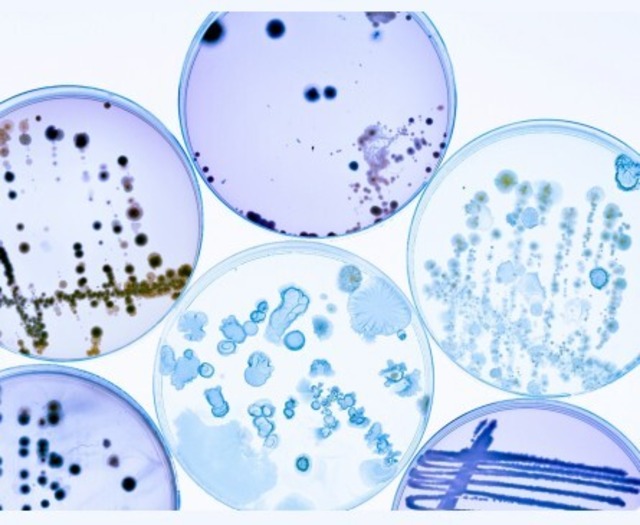

-

DR.Phage by FIDEM スキンケアローション(30ml)
¥2,200
20%OFF
20%OFF
SOLD OUT
セクシー女優・男優さん(株式会社FIDEM)と開発した、肌が命のプロも愛用するスキンケアローション!デリケート部位や全身の肌荒れケアに! 医師×早稲田大学×プロ現場開発!肌の悪玉菌に直接アプローチするバクテリオファージ配合 プロの現場でも愛用され、令和の虎からも絶賛! 予防会クリニックにおいて驚異のリピート率(90%) 全身の肌荒れに加えて、髭剃り・脱毛・剃毛など毛処理後の肌荒れ・デキモノケアにも! ■使い方 ①肌荒れ・デキモノケアに 肌荒れ・デキモノ部位に、1プッシュ程度塗ってもらうと、肌荒れ・デキモノケアとなります ②毛処理後に(髭剃り後、脱毛後、剃毛後) 処理後、1プッシュ程度塗ってもらうと、肌荒れケアとなります ③日々の美肌ケアに 洗顔後、2プッシュ程度顔全体に塗ってもらうと、肌を健やかに保ちます (顔に限らず、肌どこでも塗れます) ■サイズ ・30ml ■ お取り扱い注意事項 ・常温でも構いませんが、冷蔵庫で保存いただいた方がより効果が長持ちします。 ・全身どこでも塗れますが、目に入ったときは洗い流してください。 ・肌に異常を感じた場合は使用を中止し、専門家に相談してください。 ・この商品は全ての肌質に適しているわけではありません。お肌に合わない場合は使用を中止してください。 ■ 発送・注文に関する情報や注意事項 ・ご注文後、通常2〜5営業日以内に発送します。 ・商品到着後の返品・交換は未開封の場合に限ります。 ・送料800円かかります。 ■ 成分/製造国 ・全成分 水、BG、グリセリン、PEG/PPG/ポリブチレングリコールー8/5/3グリセリン、ペンチレングリコール、リン酸緩衝生理食塩水、DNA*、トリス緩衝生理食塩水、硫酸Mg、ゼラチン、カンゾウ根エキス、ツボクサエキス、チャ葉エキス、イタドリ根エキス、オウゴン根エキス、カミツレ花エキス、ローズマリー葉エキス、グリチルリチン酸2K、ヒアルロン酸Na、加水分解ヒアルロン酸Na、アセチルヒアルロン酸Na、ヒアルロン酸クロスポリマーー2ーNa、キサンタンガム、エチルヘキシルグリセリン、メチルパラベン *:バクテリオファージ由来 ・製造国:日本 商品の詳細やご不明点については、ショップのお問い合わせからお気軽にご連絡ください。 皆様の肌荒れのない、美肌に貢献できれば幸いです。
-

DR.Phage by FIDEMスキンケアローション(100ml)
¥4,400
20%OFF
20%OFF
SOLD OUT
セクシー女優・男優さん(株式会社FIDEM)と開発した、肌が命のプロも愛用するスキンケアローション!デリケート部位や全身の肌荒れケアに! 医師×早稲田大学×プロ現場開発!肌の悪玉菌に直接アプローチするバクテリオファージ配合 プロの現場でも愛用され、令和の虎からも絶賛! 予防会クリニックにおいて驚異のリピート率(90%) 全身の肌荒れに加えて、髭剃り・脱毛・剃毛など毛処理後の肌荒れ・デキモノケアにも! ■使い方 ①肌荒れ・デキモノケアに 肌荒れ・デキモノ部位に、1プッシュ程度塗ってもらうと、肌荒れ・デキモノケアとなります ②毛処理後に(髭剃り後、脱毛後、剃毛後) 処理後、1プッシュ程度塗ってもらうと、肌荒れケアとなります ③日々の美肌ケアに 洗顔後、2プッシュ程度顔全体に塗ってもらうと、肌を健やかに保ちます (顔に限らず、肌どこでも塗れます) ■サイズ ・100ml ■ お取り扱い注意事項 ・常温でも構いませんが、冷蔵庫で保存いただいた方がより効果が長持ちします。 ・全身どこでも塗れますが、目に入ったときは洗い流してください。 ・肌に異常を感じた場合は使用を中止し、専門家に相談してください。 ・この商品は全ての肌質に適しているわけではありません。お肌に合わない場合は使用を中止してください。 ■ 発送・注文に関する情報や注意事項 ・ご注文後、通常2〜5営業日以内に発送します。 ・商品到着後の返品・交換は未開封の場合に限ります。 ・送料800円かかります。 ■ 成分/製造国 ・全成分 水、BG、グリセリン、PEG/PPG/ポリブチレングリコールー8/5/3グリセリン、ペンチレングリコール、リン酸緩衝生理食塩水、DNA*、トリス緩衝生理食塩水、硫酸Mg、ゼラチン、カンゾウ根エキス、ツボクサエキス、チャ葉エキス、イタドリ根エキス、オウゴン根エキス、カミツレ花エキス、ローズマリー葉エキス、グリチルリチン酸2K、ヒアルロン酸Na、加水分解ヒアルロン酸Na、アセチルヒアルロン酸Na、ヒアルロン酸クロスポリマーー2ーNa、キサンタンガム、エチルヘキシルグリセリン、メチルパラベン *:バクテリオファージ由来 ・製造国:日本 商品の詳細やご不明点については、ショップのお問い合わせからお気軽にご連絡ください。 皆様の肌荒れのない、美肌に貢献できれば幸いです。
-
肌の悪玉菌検査
¥1,200
20%OFF
20%OFF
SOLD OUT
肌の悪玉菌を徹底検査!あなたの肌を守る新習慣! 肌荒れ、デキモノには肌の悪玉菌「黄色ブドウ球菌」が関与していることが多いです。アトピーやニキビの重症化にも関与しています。 この悪玉菌の量を知ることで、肌荒れの原因が悪玉菌によるものか、知ることが出来ます。 悪玉菌が多ければ、DR.Phage by FIDEMスキンケアローションが有効です。 また、DR.Phageスキンケアローションを使ってもらって、肌の悪玉菌が減ったかどうか調べてもらって、効果を確認してもらえます。 肌の状態を知り、よりよく保つためのツールとして、是非ご活用ください! ■使い方 1. 同封されている綿棒で、気になる部分(肌荒れしている部位など)を10回程度擦過してください。 2. 容器に入れて、同封されている返信用封筒で返送してください。 3. 代表が院長を務める、予防会新宿サテライトクリニックで、肌の悪玉菌「黄色ブドウ球菌」の半定量検査を行います。 4. 結果をメールでお伝えします。 ■サイズ ・検査キット1セット、返信用封筒、使い方 ■お取り扱い注意事項 ・衛生管理をしっかりと行い、使用時には清潔な手で扱ってください。 ■発送・注文に関する情報や注意事項 ・ご注文後、通常2〜5営業日以内に発送します。 ・使用後の返品・交換は未開封の場合に限ります。 ・送料は無料です。 商品の詳細やご不明点については、ショップのお問い合わせからお気軽にご連絡ください。 皆様の肌荒れのない、美肌に貢献できれば幸いです。
-

(定期便)DR.Phage by FIDEM スキンケアローション(30ml)
¥1,980
20%OFF
20%OFF
SOLD OUT
【定期便 10%引きとなります】 セクシー女優・男優さん(株式会社FIDEM)と開発した、肌が命のプロも愛用するスキンケアローション!デリケート部位や全身の肌荒れケアに! 医師×早稲田大学×プロ現場開発!肌の悪玉菌に直接アプローチするバクテリオファージ配合 プロの現場でも愛用され、令和の虎からも絶賛! 予防会クリニックにおいて驚異のリピート率(90%) 全身の肌荒れに加えて、髭剃り・脱毛・剃毛など毛処理後の肌荒れ・デキモノケアにも! ■使い方 ①肌荒れ・デキモノケアに 肌荒れ・デキモノ部位に、1プッシュ程度塗ってもらうと、肌荒れ・デキモノケアとなります ②毛処理後に(髭剃り後、脱毛後、剃毛後) 処理後、1プッシュ程度塗ってもらうと、肌荒れケアとなります ③日々の美肌ケアに 洗顔後、2プッシュ程度顔全体に塗ってもらうと、肌を健やかに保ちます (顔に限らず、肌どこでも塗れます) ■サイズ ・30ml ■ お取り扱い注意事項 ・常温でも構いませんが、冷蔵庫で保存いただいた方がより効果が長持ちします。 ・全身どこでも塗れますが、目に入ったときは洗い流してください。 ・肌に異常を感じた場合は使用を中止し、専門家に相談してください。 ・この商品は全ての肌質に適しているわけではありません。お肌に合わない場合は使用を中止してください。 ■ 発送・注文に関する情報や注意事項 ・ご注文後、通常2〜5営業日以内に発送します。 ・商品到着後の返品・交換は未開封の場合に限ります。 ・送料800円かかります。 ■ 成分/製造国 ・全成分 水、BG、グリセリン、PEG/PPG/ポリブチレングリコールー8/5/3グリセリン、ペンチレングリコール、リン酸緩衝生理食塩水、DNA*、トリス緩衝生理食塩水、硫酸Mg、ゼラチン、カンゾウ根エキス、ツボクサエキス、チャ葉エキス、イタドリ根エキス、オウゴン根エキス、カミツレ花エキス、ローズマリー葉エキス、グリチルリチン酸2K、ヒアルロン酸Na、加水分解ヒアルロン酸Na、アセチルヒアルロン酸Na、ヒアルロン酸クロスポリマーー2ーNa、キサンタンガム、エチルヘキシルグリセリン、メチルパラベン *:バクテリオファージ由来 ・製造国:日本 商品の詳細やご不明点については、ショップのお問い合わせからお気軽にご連絡ください。 皆様の肌荒れのない、美肌に貢献できれば幸いです。
-

(定期便)DR.Phageスキンケアローション(100ml)
¥3,960
20%OFF
20%OFF
SOLD OUT
【定期便 10%引きとなります】 セクシー女優・男優さん(株式会社FIDEM)と開発した、肌が命のプロも愛用するスキンケアローション!デリケート部位や全身の肌荒れケアに! 医師×早稲田大学×プロ現場開発!肌の悪玉菌に直接アプローチするバクテリオファージ配合 プロの現場でも愛用され、令和の虎からも絶賛! 予防会クリニックにおいて驚異のリピート率(90%) 全身の肌荒れに加えて、髭剃り・脱毛・剃毛など毛処理後の肌荒れ・デキモノケアにも! ■使い方 ①肌荒れ・デキモノケアに 肌荒れ・デキモノ部位に、1プッシュ程度塗ってもらうと、肌荒れ・デキモノケアとなります ②毛処理後に(髭剃り後、脱毛後、剃毛後) 処理後、1プッシュ程度塗ってもらうと、肌荒れケアとなります ③日々の美肌ケアに 洗顔後、2プッシュ程度顔全体に塗ってもらうと、肌を健やかに保ちます (顔に限らず、肌どこでも塗れます) ■サイズ ・100ml ■ お取り扱い注意事項 ・常温でも構いませんが、冷蔵庫で保存いただいた方がより効果が長持ちします。 ・全身どこでも塗れますが、目に入ったときは洗い流してください。 ・肌に異常を感じた場合は使用を中止し、専門家に相談してください。 ・この商品は全ての肌質に適しているわけではありません。お肌に合わない場合は使用を中止してください。 ■ 発送・注文に関する情報や注意事項 ・ご注文後、通常2〜5営業日以内に発送します。 ・商品到着後の返品・交換は未開封の場合に限ります。 ・送料800円かかります。 ■ 成分/製造国 ・全成分 水、BG、グリセリン、PEG/PPG/ポリブチレングリコールー8/5/3グリセリン、ペンチレングリコール、リン酸緩衝生理食塩水、DNA*、トリス緩衝生理食塩水、硫酸Mg、ゼラチン、カンゾウ根エキス、ツボクサエキス、チャ葉エキス、イタドリ根エキス、オウゴン根エキス、カミツレ花エキス、ローズマリー葉エキス、グリチルリチン酸2K、ヒアルロン酸Na、加水分解ヒアルロン酸Na、アセチルヒアルロン酸Na、ヒアルロン酸クロスポリマーー2ーNa、キサンタンガム、エチルヘキシルグリセリン、メチルパラベン *:バクテリオファージ由来 ・製造国:日本 商品の詳細やご不明点については、ショップのお問い合わせからお気軽にご連絡ください。 皆様の肌荒れのない、美肌に貢献できれば幸いです。